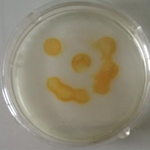
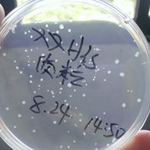

Uploads by Shizhen Wang
From OpenWetWare
Jump to navigationJump to search
This special page shows all uploaded files.
| Date | Name | Thumbnail | Size | Description |
|---|---|---|---|---|
| 06:42, 27 October 2013 | Introduction pic.gif (file) | 498 KB | ||
| 06:40, 27 October 2013 | Fig-4-5.png (file) | 68 KB | ||
| 05:51, 27 October 2013 | Fig-4-4.png (file) | 68 KB | ||
| 05:47, 27 October 2013 | Fig-4-3.png (file) | 68 KB | ||
| 05:46, 27 October 2013 | Fig-4-2.png (file) | 13 KB | ||
| 05:45, 27 October 2013 | Fig-4-1.png (file) | 10 KB | ||
| 05:40, 27 October 2013 | Fig-3-4.png (file) | 30 KB | ||
| 05:40, 27 October 2013 | Fig-3-3.png (file) | 26 KB | ||
| 04:48, 27 October 2013 | Xmu xiaohui.jpg (file) | 25 KB | ||
| 04:40, 27 October 2013 | Fig-3-1.png (file) | 50 KB | ||
| 04:38, 27 October 2013 | Fig-3-2.png (file) | 33 KB | ||
| 04:26, 27 October 2013 | Fig-1-5.png (file) | 28 KB | ||
| 04:25, 27 October 2013 | Fig-1-4.png (file) | 44 KB | ||
| 04:13, 27 October 2013 | Table-3-1.png (file) | 21 KB | ||
| 04:12, 27 October 2013 | Fig-2-2.png (file) | 73 KB | ||
| 04:11, 27 October 2013 | Fig-2-1.png (file) | 21 KB | ||
| 04:11, 27 October 2013 | Fig-1-3.png (file) | 73 KB | ||
| 04:10, 27 October 2013 | Fig-1-2.png (file) | 52 KB | ||
| 04:09, 27 October 2013 | Fig-1-1.png (file) | 70 KB | ||
| 02:40, 27 October 2013 | Ixmu-tem9.png (file) | 15 KB | ||
| 02:40, 27 October 2013 | Ixmu-tem8.png (file) | 15 KB | ||
| 02:39, 27 October 2013 | Ixmu-tem7.png (file) | 47 KB | ||
| 02:39, 27 October 2013 | Ixmu-tem6.png (file) | ![]() |
27 KB | |
| 02:38, 27 October 2013 | Ixmu-tem5.png (file) | ![]() |
31 KB | |
| 02:37, 27 October 2013 | Ixmu-tem4.png (file) | 58 KB | ||
| 02:36, 27 October 2013 | Ixmu-tem3.png (file) | ![]() |
24 KB | |
| 02:36, 27 October 2013 | Ixmu-tem2.png (file) | ![]() |
38 KB | |
| 02:33, 27 October 2013 | Ixmu-tem1.png (file) | ![]() |
24 KB | |
| 02:19, 27 October 2013 | OVERVIEW bar.png (file) | 12 KB | ||
| 02:09, 27 October 2013 | Acknowledgement bar.png (file) | 19 KB | ||
| 01:42, 27 October 2013 | Biomod 2013 Xiamen XMU-Nanobiocat Video.ogg (file) | 1.72 MB | ||
| 01:07, 27 October 2013 | Fangbaishan.jpg (file) | 89 KB | ||
| 00:25, 27 October 2013 | ACKNOWLEDGEMENTbar.png (file) | 19 KB | ||
| 00:24, 27 October 2013 | BACKGROUND bar.png (file) | 14 KB | ||
| 00:24, 27 October 2013 | REFERENCES bar.png (file) | 14 KB | ||
| 00:24, 27 October 2013 | METHODS bar.png (file) | 13 KB | ||
| 00:23, 27 October 2013 | OUR UNIVERSITY bar.png (file) | 16 KB | ||
| 00:22, 27 October 2013 | RESULT bar.png (file) | 10 KB | ||
| 00:15, 27 October 2013 | MEMBERS bar.png (file) | 12 KB | ||
| 00:10, 27 October 2013 | TEAM bar.png (file) | 12 KB | ||
| 23:05, 26 October 2013 | VIDEO bar.png (file) | 10 KB | ||
| 22:49, 26 October 2013 | ABSTRACT bar.png (file) | 12 KB | ||
| 15:25, 26 October 2013 | Xmu table3-3.jpg (file) | 38 KB | ||
| 15:25, 26 October 2013 | Xmu table2-2.jpg (file) | 41 KB | ||
| 15:21, 26 October 2013 | Xmu table1-1.jpg (file) | 37 KB | ||
| 15:18, 26 October 2013 | Xmu table1.png (file) | 37 KB | ||
| 14:32, 26 October 2013 | Xmu-example7.jpg (file) | 93 KB | ||
| 14:29, 26 October 2013 | Xmu-example6.jpg (file) | 65 KB | ||
| 14:28, 26 October 2013 | Xmu-example5.jpg (file) | 12 KB | ||
| 14:15, 26 October 2013 | Xmu-example3.jpg (file) | 39 KB |